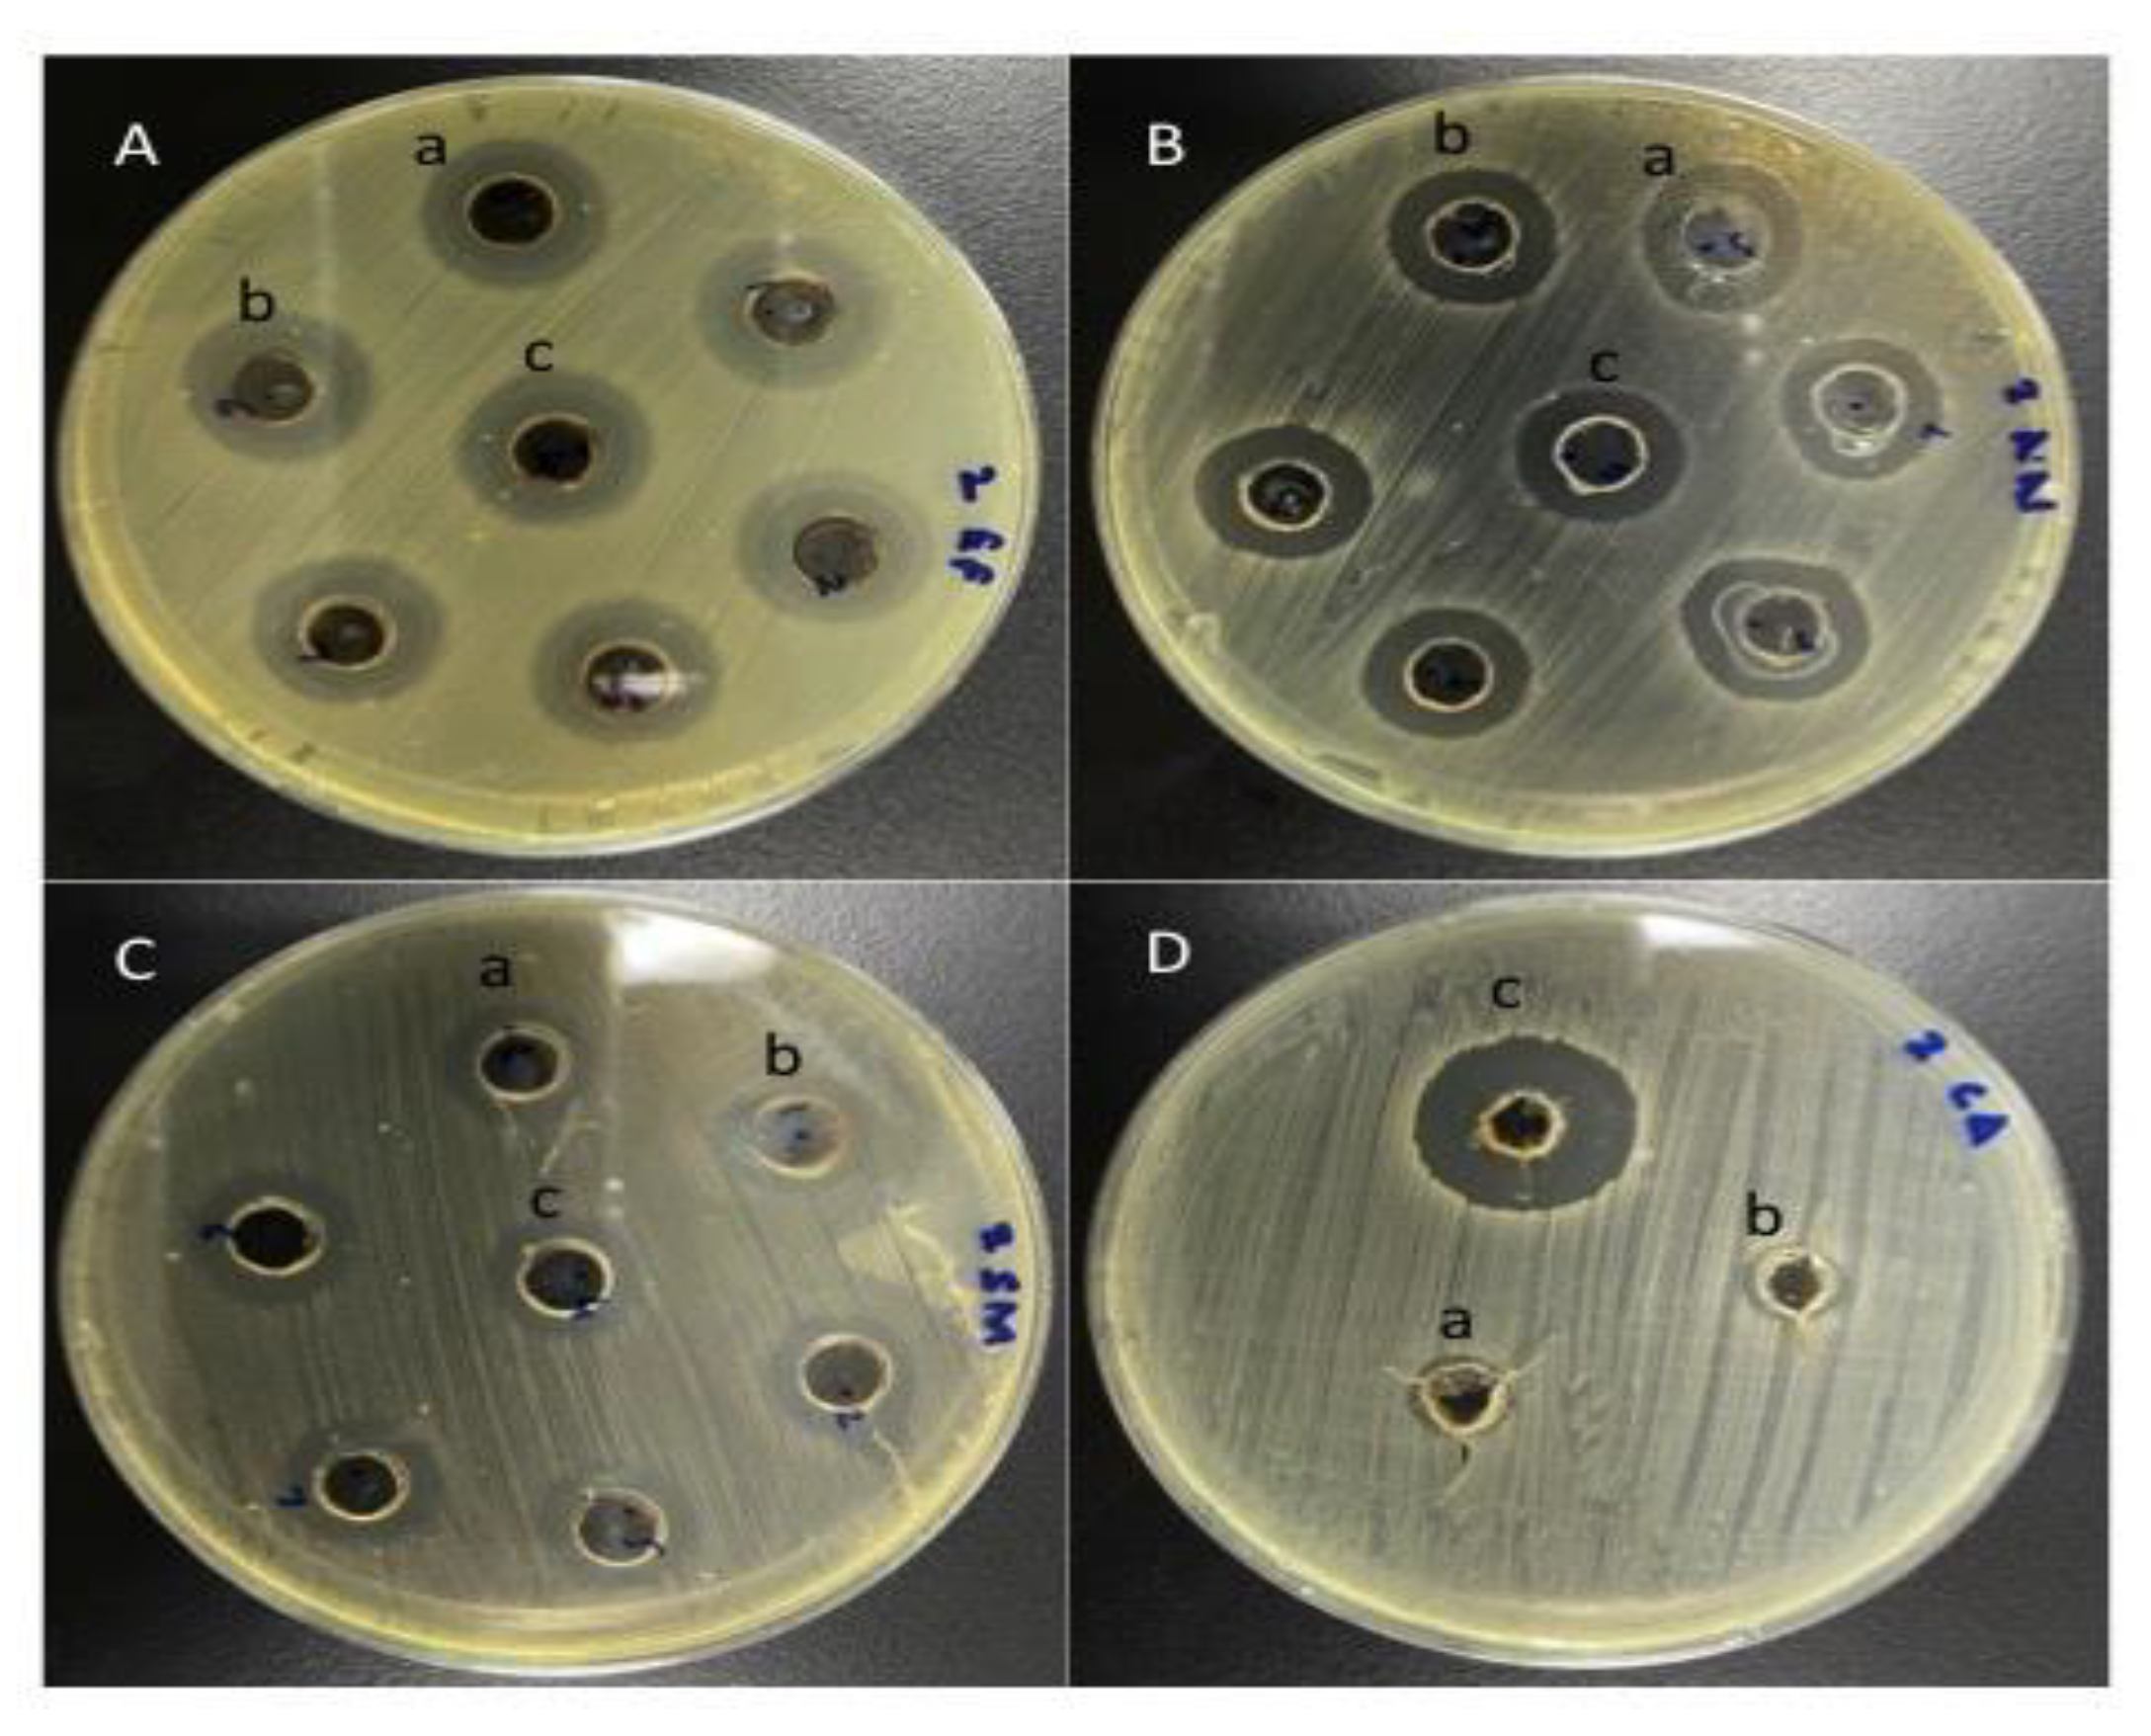
Antibiotics 10 00552 g002 Antibiotics 10 00552 g002

Synergistic Effect of Plant Extracts on Endodontic Pathogens Isolated from Teeth with Root Canal Treatment Failure: An In Vitro Study
Abstract
1. Introduction
2. Materials and Methods
2.1. Study Design and Protocol
2.2. Plants Extract Preparation
2.3. Clinical Examination and Sample Collection
2.4. Media for Microbial Growth
2.5. Biochemical Tests for Microbial Identification
2.6. Microbiological Assay
2.6.1. Antimicrobial Susceptibility Assays of the Antimicrobial Agents
2.6.2. Antimicrobial Susceptibility Assays of the Plant Extracts
2.6.3. Determination of MIC
2.6.4. Determination of MBC/MFC
2.6.5. Synergistic Antimicrobial Assays
2.7. Statistical Analysis
3. Results
3.1. Antimicrobial Activity of Antimicrobial Agents and Plant Extracts
3.2. MIC and MBC/MFC of Plant Extracts
3.3. Synergistic Activity of Plant Extracts with Antimicrobial Agents
4. Discussion
5. Conclusions
Author Contributions
Funding
Institutional Review Board Statement
Informed Consent Statement
Data Availability Statement
Acknowledgments
Conflicts of Interest
References
- Kayaoglu, G.; Orstavik, D. Virulence factors of Enterococcus faecalis: Relationship to endodontic disease. Crit. Rev. Oral Biol. Med. 2004, 15, 308–320. [Google Scholar] [CrossRef]
- Souto, R.; Colombo, A.P. Prevalence of Enterococcus faecalis in subgingival biofilm and saliva of subjects with chronic periodontal infection. Arch. Oral Biol. 2008, 53, 155–160. [Google Scholar] [CrossRef]
- Ahmad, I.; Wahab, S.; Nisar, N.; Dera, A.A.; Alshahrani, M.Y.; Abullias, S.S.; Irfan, S.; Alam, M.M.; Srivastava, S. Evaluation of antibacterial properties of Matricaria aurea on clinical isolates of periodontitis patients with special reference to red complex bacteria. Saudi Pharm. J. 2020, 28, 1203–1209. [Google Scholar] [CrossRef] [PubMed]
- Flahaut, S.; Benachour, A.; Giard, J.-C.; Boutibonnes, P.; Auffray, Y. Defence against lethal treatments and de novo pro-tein synthesis induced by NaCl in Enterococcus faecalis ATC C19433. Arch. Microbiol. 1996, 165, 317–324. [Google Scholar] [CrossRef] [PubMed]
- Flahaut, S.; Hartke, A.; Giard, J.-C.; Auffray, Y. Alkaline stressresponse in Enterococcus faecalis: Adaptation, cross-protection, and changes in protein synthesis. Appl. Environ. Microbiol. 1997, 63, 812–814. [Google Scholar] [CrossRef]
- Flahaut, S.; Hartke, A.; Giard, J.-C.; Benachour, A.; Boutibonnes, P.; Auffray, Y. Relationship between stress responsetowards bile salts, acid and heat treatment in Enterococcusfaecalis. FEMS Microbiol. Lett. 1996, 138, 49–54. [Google Scholar] [CrossRef]
- Hubble, T.S.; Hatton, J.F.; Nallapareddy, S.R.; Murray, B.E.; Gillespie, M.J. Influence of Enterococcus faecalis proteases and the collagen-binding protein, Ace, on adhesion to dentin. Oral Microbiol. Immunol. 2003, 18, 121–126. [Google Scholar] [CrossRef]
- Banerjee, T.; Anupurba, S. Prevalence of virulence factors and drug resistance in clinical isolates of Enterococci: A study from North India. J. Pathog. 2015, 2015, 692612. [Google Scholar] [CrossRef] [PubMed]
- Sberna, M.T.; Rizzo, G.; Zacchi, E.; Capparè, P.; Rubinacci, A. A preliminary study of the use of peripheral quantitative computed tomography for investigating root canal anatomy. Int. Endod. J. 2009, 42, 66–75. [Google Scholar] [CrossRef]
- Bueno, M.R.; Estrela, C.; Granjeiro, J.M.; Estrela, M.; Azevedo, B.C.; Diogenes, A. Cone-beam computed tomography cinematic rendering: Clinical, teaching and research applications. Braz. Oral Res. 2021, 35, e024. [Google Scholar] [CrossRef]
- Ahmed, H.; Ibrahim, N.; Mohamad, N.S.; Nambiar, P.; Muhammad, R.F.; Yusoff, M.; Dummer, P. Application of a new system for classifying root and canal anatomy in studies involving micro-computed tomography and cone beam computed tomography-Explanation and elaboration. Int. Endod. J. 2021. [Google Scholar] [CrossRef]
- Baumgartner, J.C.; Watts, C.M.; Xia, T. Occurrence of Candida albicans in infections of endodontic origin. J. Endod. 2000, 26, 695–698. [Google Scholar] [CrossRef] [PubMed]
- Siqueira, J.F., Jr.; Rôças, I.N. Diversity of endodontic microbiota revisited. J. Dent. Res. 2009, 88, 969–981. [Google Scholar] [CrossRef] [PubMed]
- Waltimo, T.M.; Haapasalo, M.; Zehnder, M.; Meyer, J. Clinical aspects related to endodontic yeast infections. Endod. Top. 2004, 9, 66–78. [Google Scholar] [CrossRef]
- Siqueira, J.F., Jr. Periapical actinomycosis and infection with Propionibacterium propionicum. Endod. Top. 2003, 6, 78–95. [Google Scholar] [CrossRef]
- Gomes, B.P.; Pinheiro, E.T.; Gadê-Neto, C.R.; Sousa, E.L.; Ferraz, C.C.; Zaia, A.A.; Teixeira, F.B.; Souza-Filho, F.J. Microbiological examination of infected dental root canals. Oral Microbiol. Immunol. 2004, 19, 71–76. [Google Scholar] [CrossRef]
- Chávez de Paz, L.; Svensäter, G.; Dahlén, G.; Bergenholtz, G. Streptococci from root canals in teeth with apical periodontitis receiving endodontic treatment. Oral Surg. Oral Med. Oral Pathol. Oral Radiol. Endod. 2005, 100, 232–241. [Google Scholar] [CrossRef] [PubMed]
- Almas, K. The antimicrobial effects of extracts of Azadirachta indica (neem) and Salvadora Persica (Arak) chewing sticks. Indian J. Dent. Res. 1999, 10, 23–26. [Google Scholar]
- Halawany, H.S. A review on miswak (Salvadora persica) and its effect on various aspects of oral health. Saudi Dent. J. 2012, 24, 63–69. [Google Scholar] [CrossRef]
- Haque, M.M.; Alsareii, S.A. A review of the therapeutic effects of using miswak (Salvadora Persica) on oral health. Saudi Med. J. 2015, 36, 530–543. [Google Scholar] [CrossRef]
- Dolara, P.; Corte, B.; Ghelardini, C.; Pugliese, A.M.; Cerbai, E.; Menichetti, S.; Lo Nostro, A. Local anaesthetic, antibacterial and antifungal properties of sesquiterpenes from myrrh. Planta Med. 2000, 66, 356–358. [Google Scholar] [CrossRef] [PubMed]
- Ghonmode, W.N.; Balsaraf, O.D.; Tambe, V.H.; Saujanya, K.P.; Patil, A.K.; Kakde, D.D. Comparison of the antibacterial efficacy of neem leaf extracts, grape seed extracts and 3% sodium hypochlorite against E. faecalis—An in vitro study. J. Int. Oral Health 2013, 5, 61–66. [Google Scholar]
- Ahmad, I. Antibacterial activity of Nepeta deflersiana extract against pathogenic Gram-positive bacteria. Res. J. Biotechnol. 2019, 14, 43–51. [Google Scholar]
- Kaufman, B.; Spångberg, L.; Barry, J.; Fouad, A.F. Enterococcus spp. in endodontically treated teeth with and without periradicular lesions. J. Endod. 2005, 31, 851–856. [Google Scholar] [CrossRef]
- Dugas, N.N.; Lawrence, H.P.; Teplitsky, P.E.; Pharoah, M.J.; Friedman, S. Periapical health and treatment quality assessment of root-filled teeth in two Canadian populations. Int. Endod. J. 2003, 36, 181–192. [Google Scholar] [PubMed]
- Al-Kuraishy, H.M.; Al-Gareeb, I.; Albuhadilly, K.A.; Alwindy, S. In vitro assessment of the antibacterial activity of Matricaria chamomile alcoholic extract against pathogenic bacterial strains. Br. Microbiol. Res. J. 2015, 7, 55–61. [Google Scholar] [CrossRef]
- Ahmad, A.; van Vuuren, S.; Viljoen, A. Unravelling the complex antimicrobial interactions of essential oils-the case of Thymus vulgaris (Thyme). Molecules 2014, 19, 2896–2910. [Google Scholar]
- Capparè, P.; Tetè, G.; Sberna, M.T.; Panina-Bordignon, P. The Emerging Role of Stem Cells in Regenerative Dentistry. Curr. Gene Ther. 2020, 20, 259–268. [Google Scholar] [PubMed]
- Khazaei, S.; Keshavarz, G.; Bozorgi, A.; Nazari, H.; Khazaei, M. Adipose tissue-derived stem cells: A comparative review on isolation, culture, and differentiation methods. Cell Tissue Bank 2021. [Google Scholar] [CrossRef]
- Sanz, J.L.; Rodríguez-Lozano, F.J.; Lopez-Gines, C.; Monleon, D.; Llena, C.; Forner, L. Dental stem cell signaling pathway activation in response to hydraulic calcium silicate-based endodontic cements: A systematic review of in vitro studies. Dent. Mater. 2021, 37, e256–e268. [Google Scholar] [PubMed]
- Peciuliene, V.; Reynaud, A.H.; Balciuniene, I.; Haapasalo, M. Isolation of yeasts and enteric bacteria in root-filled teeth with chronic apical periodontitis. Int. Endod. J. 2001, 34, 429–434. [Google Scholar] [CrossRef] [PubMed]
- Pinheiro, E.T.; Gomes, B.P.; Ferraz, C.C.; Sousa, E.L.; Teixeira, F.B.; Souza-Filho, F.J. Microorganisms from canals of root-filled teeth with periapical lesions. Int. Endod. J. 2003, 36, 1–11. [Google Scholar] [CrossRef] [PubMed]
- Waltimo, T.M.; Sen, B.H.; Meurman, J.H.; Ųrstavik, D.; Haapasalo, M.P. Yeasts in apical periodontitis. Crit. Rev. Oral Biol. Med. 2003, 14, 128–137. [Google Scholar] [CrossRef]
- Pinheiro, E.T.; Gomes, B.P.; Ferraz, C.C.; Teixeira, F.B.; Zaia, A.A.; Souza Filho, F.J. Evaluation of root canal microorganisms isolated from teeth with endodontic failure and their antimicrobial susceptibility. Oral Microbiol. Immunol. 2003, 18, 100–103. [Google Scholar] [CrossRef]
- Siqueira, J.F.; Rôças, I. Polymerase chain reaction-based analysis of microorganisms associated with failed endodontic treatment. Oral Surg. Oral Med. Oral Pathol. Oral Radiol. Endod. 2004, 97, 85–94. [Google Scholar]
- Sundqvist, G.; Figdor, D.; Persson, S.; Sjögren, U. Microbiologic analysis of teeth with failed endodontic treatment and the outcome of conservative re-treatment. Oral Surg. Oral Med. Oral Pathol. Oral Radiol. Endod. 1998, 85, 86–93. [Google Scholar]
- Rôças, I.N.; Siqueira, J.F.; Santos, K.R.N. Association of Enterococcus faecalis with different forms of periradicular diseases. J. Endod. 2004, 30, 315–320. [Google Scholar] [PubMed]
- Nikawa, H.; Nishimura, H.; Hamada, T.; Makihira, S.; Samaranayake, L.P. Relationship between thigmotropism and candida biofilm formation in vitro. Mycopathologia 1998, 144, 125–129. [Google Scholar] [CrossRef]
- Davies, J.M.; Stacey, A.J.; Gilligan, C.A. Candida albicans hyphal invasion: Thigmotropism or chemotropism? FEMS Microbiol. Lett. 1999, 171, 245–249. [Google Scholar]
- Jaisinghani, R.N.; Makhwana, S.; Kanojia, A. Study on antibacterial and flavonoid content of ethanolic extract of Punica granatum (pomegranate) peel. Microbiol. Res. 2018, 9, 6–9. [Google Scholar]
- Lakshmi, T.; Aravind, K.S. Antibacterial evaluation of AzadirachtaIndica ethanolic leaf extract against selected acidogenic oral bacteria causing dental plaque in fixed orthodontic appliance patients—An Invitro study. Int. J. Bot. Res. 2012, 1, 30–40. [Google Scholar]
- Kuete, V. Potential of Cameroonian plants and derived products against microbial infections: A review. Planta Med. 2010, 76, 1479–1491. [Google Scholar] [CrossRef] [PubMed]
- Saquib, S.A.; AlQahtani, N.A.; Ahmad, I.; Kader, M.A.; Al Shahrani, S.S.; Asiri, E.A. Evaluation and Comparison of Antibacterial Efficacy of Herbal Extracts in Combination with Antibiotics on Periodontal pathobionts: An in vitro Microbiological Study. Antibiotics 2019, 1, 89. [Google Scholar] [CrossRef]
- Arévalo-Híjar, L.; Aguilar-Luis, M.Á.; Caballero-García, S.; Gonzáles-Soto, N.; Valle-Mendoza, D. Antibacterial and Cytotoxic Effects of Moringa oleifera (Moringa) and Azadirachta indica (Neem) Methanolic Extracts against Strains of Enterococcus faecalis. Int. J. Dent. 2018, 3, 1–5. [Google Scholar] [CrossRef] [PubMed]
- Chandrappa, P.M.; Dupper, A.; Tripathi, P.; Arroju, R.; Sharma, P.; Sulochana, K. Antimicrobial activity of herbal medicines (tulsi extract, neem extract) and chlorhexidine against Enterococcus faecalis in Endodontics: An in vitro study. J. Int. Soc. Prevent. Community Dent. 2015, 5 (Suppl. 2), S89–S92. [Google Scholar]
- Mistry, K.S.; Sanghvi, Z.; Parmar, G.; Shah, S. The antimicrobial activity of Azadirachta indica, Mimusops elengi, Tinospora cardifolia, Ocimum sanctum and 2% chlorhexidine gluconate on common endodontic pathogens: An in vitro study. Eur. J. Dent. 2014, 8, 172–177. [Google Scholar] [CrossRef]
- Tyagi, S.P.; Sinha, D.J.; Garg, P.; Singh, U.P.; Mishra, C.C.; Nagpal, R. Comparison of antimicrobial efficacy of propolis, Morinda citrifolia, Azadirachta indica (Neem) and 5% sodium hypochlorite on Candida albicans biofilm formed on tooth substrate: An in-vitro study. J. Conserv. Dent. 2013, 16, 532–535. [Google Scholar]
- Monawer, A.T. Role of Salvadora persica in eradication of Enterococcus faecalis isolated from infected dental pulp/in vitro study. Res. J. Pharm. Biol. Chem. Sci. 2018, 9, 1665–1670. [Google Scholar]
- Ahmad, I.; Irfan, S.; Abohashrh, M.; Wahab, S.; Abullais, S.S.; Javali, M.A.; Nisar, N.; Alam, M.M.; Srivastava, S.; Saleem, M.; et al. Inhibitory Effect of Nepeta deflersiana on Climax Bacterial Community Isolated from the Oral Plaque of Patients with Periodontal Disease. Molecules 2021, 26, 202. [Google Scholar]
- Al-Madi, E.M.; Almohaimede, A.A.; Al-Obaida, M.I.; Awaad, A.S. Comparison of the Antibacterial Efficacy of Commiphora molmol and Sodium Hypochlorite as Root Canal Irrigants against Enterococcus faecalis and Fusobacterium nucleatum. Evid. Based Complement. Alternat. Med. 2019, 2019, 6916795. [Google Scholar]
- Rafiq, Z.; Narasimhan, S.; Haridoss, M.; Vennila, R.; Vaidyanathan, R. Punica granatum rind extract: Antibiotic potentiator and efflux pump inhibitor of multidrug resistant Klebsiella pneumoniae clinical isolates. Asian J. Pharm. Clin. Res. 2017, 10, 1–5. [Google Scholar] [CrossRef][Green Version]
- Cristo, J.S.; Matias, E.F.; Figueredo, F.G.; Santos, J.F.; Pereira, N.L.; Junior, J.G.; Aquino, P.E.; Nogueira, M.N.; Ribeiro-Filho, J.; Cunha, F.A.; et al. HPLC profile and antibiotic-modifying activity of Azadirachtaindica A. Juss (Meliaceae). Ind. Crop. Prod. 2016, 94, 903–908. [Google Scholar] [CrossRef]
- Jungermann, G.B.; Burns, K.; Nandakumar, R.; Tolba, M.; Venezia, R.A.; Fouad, A.F. Antibiotic resistance in primary and persistent endodontic infections. J. Endod. 2001, 37, 1337–1344. [Google Scholar] [CrossRef]
- Skučait, N.; Pečiulien, V.; Manelien, R.; Mačiulskien, V. Antibiotic prescription for the treatment of endodontic pathology: A survey among Lithuanian dentists. Medicina 2010, 46, 806–813. [Google Scholar] [CrossRef]
- Al-Ahmad, A.; Ameen, H.; Pelz, K.; Karygianni, L.; Wittmer, A.; Anderson, A.C.; Spitzmüller, B.; Hellwig, E. Antibiotic resistance and capacity for biofilm formation of different bacteria isolated from endodontic infections associated with root-filled teeth. J. Endod. 2014, 40, 223–230. [Google Scholar] [CrossRef] [PubMed]
- MacNeill, S.; Rindler, E.; Walker, A.; Brown, A.R.; Cobb, C.M. Effects of tetracycline hydrochloride and chlorhexidine gluconate on Candida albicans. An in vitro study. J. Clin. Periodontol. 1997, 24, 753–760. [Google Scholar] [CrossRef] [PubMed]

| Organisms | Media |
|---|---|
| E. faecalis | Enterococcosel agar (BBL Microbiological Systems, Cockeysville, MD, USA) |
| A. neslundii | Brain heart infusion agar (BHI agar, HiMedia, Mumbai, India) supplemented with 10% defibrinated sheep blood |
| S. mitis | Brain heart infusion agar/broth |
| C. albicans | Blood agar (Merck, Germany) |
| Organisms | Penicillin (10 µg) | Tetracycline (30 µg) | Ofloxacin (5 µg) | ||||||
|---|---|---|---|---|---|---|---|---|---|
| Zone (mm) Mean ± SD | MIC (µg/mL) Mean ± SD | MBC (µg/mL) Mean ± SD | Zone (mm) Mean ± SD | MIC (µg/mL) Mean ± SD | MBC (µg/mL) Mean ± SD | Zone (mm) Mean ± SD | MIC (µg/mL) Mean ± SD | MBC (µg/mL) Mean ± SD | |
| E. faecalis | 15 ± 2.65 (S) | 5.5 ± 1.5 | 12 ± 2.25 | 0 (R) | 8 ± 0.75 | 14.25 ± 1.35 | 17 ± 2.65 (S) | 6 ± 1.65 | 10.28 ± 3.25 |
| A. neslundii | 13 ± 1.5 (S) | 2 ± 1.5 | 4.3 ± 0.69 | 3 ± 0.5 (R) | 2 ± 1.45 | 4.34 ± 0.85 | 15 ± 1.5 (S) | 2 ± 0.75 | 5.5 ± 1.65 |
| S. mitis | 0 (R) | - | - | 0 (R) | - | - | 2 ± 0.75 (R) | 1.9 ± 1.35 | 4.3 ± 3.47 |
| Organisms | Fluconazole (10 µg) | ||
|---|---|---|---|
| Zone (mm) Mean ± SD | MIC (µg/mL) Mean ± SD | MFC (µg/mL) Mean ± SD | |
| C. albicans | 24 ± 2.75 (S) | 1 ± 0.05 | 2.15 ± 0.35 |
| Organisms | A. indica | S. persica | C. molmol | |||||||
|---|---|---|---|---|---|---|---|---|---|---|
| Zone (mm) Mean ± SD | MIC (mg/mL) Mean ± SD | MBC/MFC (mg/mL) Mean ± SD | Zone (mm) Mean ± SD | MIC (mg/mL) Mean ± SD | MBC/MFC (mg/mL) Mean ± SD | Zone (mm) Mean ± SD | MIC (mg/mL) Mean ± SD | MBC/MFC (mg/mL) Mean ± SD | p-Value | |
| E. faecalis | 14 ± 1.5 | 0.09 ± 1.2 | 0.78 ± 1.25 | 13 ± 1.75 | 6.25 ± 2.25 | 100 ± 1.75 | 17 ± 1.25 | 6.25 ± 1.50 | 100 ± 2.0 | 0.038 |
| A. neslundii | 9 ± 1.0 | 4 ± 0.5 | 16 ± 0.65 | 20 ± 2.0 | 8.65 ± 0.50 | 12.34 ± 1.0 | 13 ± 0.75 | 12.5 ± 3.25 | 100 ± 3.75 | 0.013 |
| S. mitis | 10 ± 0.75 | 6.25 ± 0.24 | 100 ± 2.5 | 12 ± 1.25 | 6.25 ± 1.5 | 50 ± 1.5 | 15 ± 2.75 | 3.25 ± 2.25 | 50 ± 2.25 | 0.031 |
| C. albicans | - | - | - | - | - | - | 14 ± 0.68 | 3.12 ± 0.75 | 25 ± 1.5 | 0.179 |
| Organisms | Antibiotics | MIC of Antimicrobial Agents (μg/ mL) | MIC of A. indica (mg/mL) | FICI | Interpretation | ||
|---|---|---|---|---|---|---|---|
| Alone | Combination | Alone | Combination | ||||
| E. faecalis | Penicillin | 5.5 | 2.5 | 0.9 | 0.035 | 0.83 | Additive |
| Tetracycline | 8 | 4 | 0.9 | 0.042 | 0.96 | Additive | |
| Ofloxacin | 6 | 3.75 | 0.9 | 0.06 | 0.88 | Additive | |
| A. naeslundii | Penicillin | 2 | 1.5 | 4 | 1.95 | 1.23 | Indifferent |
| Tetracycline | 2 | 0.75 | 4 | 3.25 | 1.18 | Indifferent | |
| Ofloxacin | 2 | 1.25 | 4 | 1.55 | 1.005 | Indifferent | |
| S. mitis | Penicillin | − | − | − | − | − | − |
| Tetracycline | − | − | − | − | − | − | |
| Ofloxacin | 1.9 | 0.65 | 6.25 | 1.75 | 0.62 | Additive | |
| Organisms | Antibiotics | MIC of Antimicrobial Agents (μg/ mL) | MIC of S. persica (mg/mL) | FICI | Interpretation | ||
|---|---|---|---|---|---|---|---|
| Alone | Combination | Alone | Combination | ||||
| E. faecalis | Penicillin | 5.5 | 2.5 | 6.25 | 2.15 | 0.79 | Additive |
| Tetracycline | 8 | 4 | 6.25 | 4.25 | 1.18 | Indifferent | |
| Ofloxacin | 6 | 3.75 | 6.25 | 3.5 | 1.185 | Indifferent | |
| A. naeslundii | Penicillin | 2 | 1.5 | 8.65 | 8.65 | 1.75 | Indifferent |
| Tetracycline | 2 | 0.75 | 8.65 | 2.35 | 0.64 | Additive | |
| Ofloxacin | 2 | 1.25 | 8.65 | 2.5 | 0.91 | Additive | |
| S. mitis | Penicillin | − | − | − | − | − | − |
| Tetracycline | − | − | − | − | − | − | |
| Ofloxacin | 1.9 | 0.65 | 6.25 | 0.95 | 0.49 | Synergistic | |
| Organisms | Antibiotics | MIC of Antimicrobial Agents (μg/ mL) | MIC of C. molmol (mg/mL) | FICI | Interpretation | ||
|---|---|---|---|---|---|---|---|
| Alone | Combination | Alone | Combination | ||||
| E. faecalis | Penicillin | 5.5 | 2.5 | 6.25 | 0.40 | 0.51 | Additive |
| Tetracycline | 8 | 4 | 6.25 | 0.45 | 0.57 | Additive | |
| Ofloxacin | 6 | 3.75 | 6.25 | 0.58 | 0.71 | Additive | |
| A. naeslundii | Penicillin | 2 | 1.5 | 12.5 | 0.25 | 1.25 | Indifferent |
| Tetracycline | 2 | 0.75 | 12.5 | 2.21 | 0.54 | Additive | |
| Ofloxacin | 2 | 1.25 | 12.5 | 9.75 | 1.40 | Indifferent | |
| S. mitis | Penicillin | − | − | − | − | − | − |
| Tetracycline | − | − | − | − | − | − | |
| Ofloxacin | 1.9 | 0.65 | 3.25 | 0.5 | 0.49 | Synergistic | |
| C. albicans | Fluconazole | 1 | 0.31 | 3.12 | 0.44 | 0.45 | Synergistic |
Publisher’s Note: MDPI stays neutral with regard to jurisdictional claims in published maps and institutional affiliations. |
© 2021 by the authors. Licensee MDPI, Basel, Switzerland. This article is an open access article distributed under the terms and conditions of the Creative Commons Attribution (CC BY) license (https://creativecommons.org/licenses/by/4.0/).
Share and Cite
Arora, S.; Saquib, S.A.; Algarni, Y.A.; Kader, M.A.; Ahmad, I.; Alshahrani, M.Y.; Saluja, P.; Baba, S.M.; Abdulla, A.M.; Bavabeedu, S.S. Synergistic Effect of Plant Extracts on Endodontic Pathogens Isolated from Teeth with Root Canal Treatment Failure: An In Vitro Study. Antibiotics 2021, 10, 552. https://doi.org/10.3390/antibiotics10050552
Arora S, Saquib SA, Algarni YA, Kader MA, Ahmad I, Alshahrani MY, Saluja P, Baba SM, Abdulla AM, Bavabeedu SS. Synergistic Effect of Plant Extracts on Endodontic Pathogens Isolated from Teeth with Root Canal Treatment Failure: An In Vitro Study. Antibiotics. 2021; 10(5):552. https://doi.org/10.3390/antibiotics10050552
Chicago/Turabian StyleArora, Suraj, Shahabe Abullais Saquib, Youssef A Algarni, Mohammed Abdul Kader, Irfan Ahmad, Mohammad Y Alshahrani, Priyanka Saluja, Suheel Manzoor Baba, Anshad M. Abdulla, and Shashit Shetty Bavabeedu. 2021. "Synergistic Effect of Plant Extracts on Endodontic Pathogens Isolated from Teeth with Root Canal Treatment Failure: An In Vitro Study" Antibiotics 10, no. 5: 552. https://doi.org/10.3390/antibiotics10050552
APA StyleArora, S., Saquib, S. A., Algarni, Y. A., Kader, M. A., Ahmad, I., Alshahrani, M. Y., Saluja, P., Baba, S. M., Abdulla, A. M., & Bavabeedu, S. S. (2021). Synergistic Effect of Plant Extracts on Endodontic Pathogens Isolated from Teeth with Root Canal Treatment Failure: An In Vitro Study. Antibiotics, 10(5), 552. https://doi.org/10.3390/antibiotics10050552

